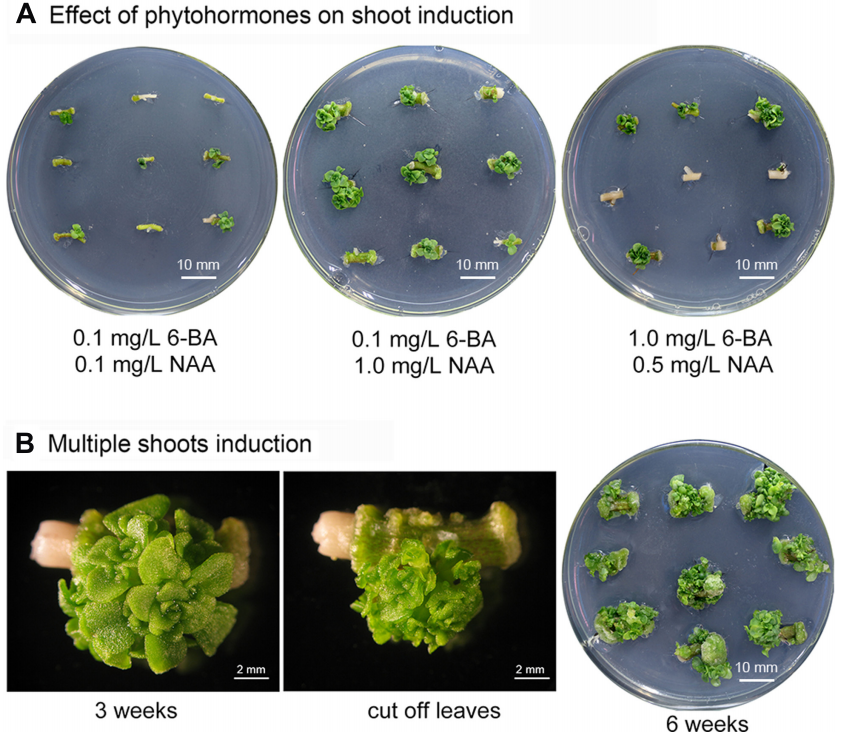

文章的整体思路:

植物细胞“全能性”的发现是植物组织培养技术发展的基础,从这一学说的提出到如今组培技术的广泛应用,已经过去了100多年。现在大家一提起转基因技术,就很自然的想起要做植物组织培养,进行遗传转化。然而,传统的组培技术并不是适用于所有的物种,即使在模式植物中该技术的应用也存在一定的限制。这篇文章想给大家介绍几种植物遗传转化的新思路,不知道在未来发展的几十年里,是否会有更好的技术横空出世,完美解决植株遗传转化中的问题。
01
背景介绍
1.1传统的植物组织培养技术
植物组织培养(Plants tissue culture)是指在无菌的条件下,将离体的植物器官(根、茎、叶、花、果实、种子等)、组织(形成层、花药组织、胚乳、皮层等)、细胞(体细胞和生殖细胞)以及原生质体,培养在人工配制的培养基上,给予适当的培养条件,诱导其产生愈伤组织、丛芽,最终形成完整的植株,是一种获得外源基因稳定转化的技术方法。
大体的过程可分为:

图1 植物组织培养大体过程。
农杆菌介导的遗传转化,是目前最常见的一种遗传转化方法。相比于基因枪法,农杆菌介导转化的外源基因大多数是单拷贝,遗传稳定性好,而且所需的仪器设备较为简单,操作易行,成本也较低。
然而不同植物的细胞和器官再生能力不同,使得农杆菌对于不同的物种侵染效率不同,在同一物种的不同品种之间也存在着较大的差异,即使是在拟南芥、水稻等模式植物中,由于基因型的限制,这一技术的应用还是存在着一定的难点。另外不得不提的是,这一技术在很多物种中尚未寻找到能够进行遗传转化的体系。
遗传转化技术的限制对于功能基因相关的研究势必会带来一定的影响,科研工作者就开始了新的探寻,旨在寻找到更好的技术来推动科研前进的齿轮。
1.2发育调节因子
科学家发现当植物经过脱分化,由体细胞转化为胚胎细胞的时候,植物体内的某些基因会被特异性的激活或者差异表达,从而使得细胞发生重编程并且获得胚胎或者分生组织,这些基因通常编码转录因子或者信号蛋白,被统称为发育调节因子(Developmental Regulators, DR)(何伟等, 2022)。
科研工作者利用发育调节因子开始了对植物遗传转化效率的增速。目前较为常见的发育调控因子有WUS2(WUSCHEL2)、BBM(Baby boom)、GRFs(growth-regulating factors)以及WOX5(WUECHEL-related homeobox 5),其中WUS和BBM,由于在决定细胞全能性方面发挥着巨大的作用,因此被称为是“明星”调控因子。
WUS编码一种同源异型结构域转录因子,是维持茎尖分生组织中干细胞生态位、侧向原基分化和植物细胞全能性等多种细胞过程的必需基因(Zuo et al., 2002)。该基因最先在拟南芥中克隆出来,它的同源基因也随后在玉米、水稻等植物中被鉴定出来。
BBM编码一个AP2/ERF转录因子,是植物细胞全能性的关键调节因子,在维持干细胞不分化状态中发挥着重要的作用(Jha et al., 2018)。该基因最初是在甘蓝型油菜中获得。
在这里就不再过多的阐述这两种发育调节因子具体的作用机理,借用文献中的一张图,向大家展示,如果有感兴趣的老师,可以自行查阅。

图2 发育调节因子BBM和WUS促进细胞去分化和体细胞胚形成功能示意图(何伟等, 2022)。
GRFs是植物特异性转录因子,GRF蛋白具有两个高度保守的功能结构域,而且能够与转录辅因子GIF(GRF-interacting factor)互作,形成一个功能性转录复合物(Kim., 2019)。它们能够调节干细胞,促进细胞增殖。

图3 GRF-GIF组合的分子生物学功能概述(Kim., 2019)。GRF-GIF组合的分子生物学功能概述。圆圈描绘了这对组合的核心和共同分子特征,其中与SWI2/SNF2复合物相关的GRF-GIF组合对靶基因进行转录调控,包括其自身(自激活),miR396转录后抑制GRF表达。单子叶植物和双子叶植物共有的生物学功能用红色表示,即通过调节细胞周期和促进根分生组织区细胞周期来促进叶片生长;在拟南芥和其他植物中确认的生物学功能分别用绿色和黑色表示;在水稻和玉米中验证的生物学功能分别用棕色和蓝色表示。黑色箭头和长方形框分别表示经过实验验证的促进和抑制作用,虚线表示推测的可能作用机制。
WOX转录因子家族具有同源异型结构域,能够与特定的DNA序列结合。WUS基因是最早发现的WOX家族成员。该家族成员主要在分裂旺盛的细胞群中表达,在植物生长发育过程中有很重要的作用,能够促进细胞分裂、维持干细胞稳定性,并且胚胎的发育和形成等等都与它有关(Cheng et al., 2014)。这类转录因子的作用机制往往通过激活或抑制下游非细胞自主性因子基因的表达,或者通过与某些发育信号分子形成负反馈调控网络来发挥调控发育的功能(何伟等, 2022)。

图4 WOX基因促进植株转化功能示意图(何伟等,2022)。
02
无需愈伤的遗传转化方法
2.1Fast-TrACC和DD
2023年10月,明尼苏达大学基因组工程中心的Daniel F. Voytas团队在国际著名期刊Nature Protocols在线发表了题为“Direct delivery and fast-treated Agrobacterium co-culture (Fast-TrACC) plant transformation methods for Nicotiana benthamiana”的研究论文。在这篇论文中,作者提出了基于农杆菌的两种快速进行植物遗传转化的新方法“Fast-TrACC”和“DD”。
Fast-TrACC是Fast-treated Agrobacterium co-culture的缩写,该方法借助于农杆菌将发育调节因子递送到无菌苗中,经过分生组织产生后,最终形成完整的再生植株。

图5 Fast-TrACC过程及样本生长情况(Cody et al., 2023)。(a)本氏烟草种子在无菌的六孔板中发芽;(b)一旦子叶长出来,如单孔特写所示,将其从液体培养基中取出,代之以处理过的农杆菌培养物;(c)共培养2d后,用水冲洗幼苗,将单株苗转移到12孔板中;(d)约20d后,幼苗开始形成绿色生长(白色箭头)。这些生长可以在幼苗(e)上保持,也可以移走并转移到1/2MS固体培养基(f)上。在幼苗上直接观察到芽萌发现象(e,白色箭头);然而,大多数新生生长物在萌芽的情况下继续增加质量(e,黑色箭头);(f)将新生苗转移到1/2MS培养基上,可促进新梢发育;(g)生根后,可将植株移栽到诱导生根培养基中,促进根系形成;(h)最后,根系已建立的植株可转移到土壤中进一步生长。
DD是Direct Delivery的缩写,称为直接递送,是将发育调节因子递送到已经去除分生组织的在土壤种植的植物中,发育调节因子可以促进伤口处细胞的分化和芽的形成,然后完成基因的转化。这一方法是在非无菌条件下进行。

图6 DD过程及样本生长情况(Cody et al., 2023)。(a)单株本氏烟草在至少3英寸的花盆中种植。当腋芽发育时,就表示植株足够成熟了;(b)用手术刀切除所有现有的分生组织(茎尖和腋窝分生组织);(c)修剪后,植株有2-3个节和一些叶片,没有明显的茎分生组织;(d,e)用注射器将农杆菌培养物输送到叶腋和所有伤口部位(茎尖和腋窝分生组织部位,e中的白色箭头);(f-h)20天剔除期后出现的芽的例子;其中包括野生型(f)和编辑过的(g)芽。由于DR的组成性过度表达,一些芽可能会出现形态异常(h)。
这两种方法与标准的组织培养方法相比,成本更低,技术难度更小,所需时间也会有所缩减。为植物遗传转化提供了新的思路。
2.2CDB递送系统
2022年10月,南方科技大学朱健康院士团队在The innovation杂志上在线发表了题为“Cut-dip-budding delivery system enables genetic modifications in plants without tissue culture”的研究论文。在这篇文章中,作者描述了一种无需组织培养,即可实现植物体内基因转化或编辑的简单方法,Cut-dip-budding被称为切-浸-萌芽(CDB)递送系统。
这一方法主要利用发根农杆菌,针对具有根蘖(指能够从根上的不定芽原基发育成芽)能力的植株。利用发根农杆菌侵染切后的根茎交界部位,植株的茎随后会产生转化根,继而再由转化根产生转化的植株。在文中,作者利用这种方法完成了多个物种的遗传转化,包括橡胶草、小冠花、甘薯、臭椿、辽东楤木及重瓣臭茉莉。
接下来以橡胶草(T. kok-saghyz Rodin (TKS))为例,向大家介绍一下CDB递送系统。

图7 CDB递送系统与橡胶草的遗传转化(Cao et al., 2022)。(A)CDB递送系统的工作流程。将3-4周龄的幼苗扦插作为外植体,报告基因或基因编辑载体通过根状芽孢杆菌传递到切口附近的植物细胞中,几周后形成毛状根。将GFP阳性的根切段培养,产生转基因阳性或基因编辑的芽;(B)3-4周龄的幼苗;(C)外植体。白色箭头表示感染部位;(D)接种农杆菌的外植体在蛭石中培养;(E和F)GFP阳性的TKS毛状根形成;(G和H)阳性毛状根继续发育;(I和J)GFP阳性根段;(K和L)在GFP阳性根段上形成转基因阳性芽;(M)在土壤中种植的转化芽正常生长到繁殖阶段;在(E)、(F)、(I)、(J)、(K)和(L)中,左边的样本是未变换的对照。在(F)、(H)、(J)和(L)中,用荧光灯照射样品。红色箭头表示转化组织中的GFP荧光。比例尺:1厘米。
这一方法的创制,对于那些具有根蘖性植株来说是一种简便快速的遗传转化方法,有望通过这一系统实现对这些植株类群的遗传改良。
2.3景天属植物遗传转化
2017年6月,中国科学院植物研究所徐文忠团队在Frontiers in plant science杂志上,发表了一篇题为“A genetic transformation method for cadmium hyperaccumulator Sedum plumbizincicola and non-hyperaccumulating ecotype of Sedum alfredii”的研究论文。文中提出了一种针对景天属植物,无需愈伤组织的遗传转化方式。
利用景天属植物的茎段来诱导丛芽的生成,继而得到分生组织,随后利用分生组织与重组农杆菌进行共培养,诱导出芽。最后取生芽的分生组织,诱导生根,完成整个转化的过程。
图8 多枝景天芽的诱导(Liu et al., 2017)。(A)茎外植体在含有不同浓度6-BA和NAA的培养基上生长。(B)在含有0.1mg/L 6-BA和1.0mg/L NAA的培养基上诱导出多芽。
这是一种无愈伤组织的简单、高效且专属于景天属植物的遗传转化方法,不仅可以对遗传转化过程进行提速,而且考虑到景天属植物属于天冬氨酸代谢植物,这一方法的建立对于研究临时二氧化碳泵的分子机制等方面有很大的推动作用。
2.4水稻切口胚芽转化
2023年10月,Molecular Biology Reports杂志发表了一篇题为“Agrobacterium‐mediated in planta transformation of cut coleoptile: a new, simplified, and tissue culture‐independent method to deliver the CRISPR/Cas9 system in rice”的研究论文,论文中开发了一种无需组织培养就能够在水稻中实现遗传转化的技术。
研究者将带切口胚芽的萌发种子作为农杆菌侵染的目标,完成了对CRISPR/Cas系统的导入,在受体品种马来西亚水稻M219的基因组中检测到了Cas蛋白的存在,表明了这一方法的成功。

图9 胚芽切除后芽发育的活力测定。用无菌刀片去除胚芽,保留胚根。所有部分胚芽被切除的幼苗在4天后都成功地长出了绿叶。
对于开发水稻遗传转化的新方法,科研工作者一直在不断地创新和尝试。针对籼稻的遗传转化,曾经利用无菌针刺穿胚,以促进农杆菌渗透,但这种方法对于不同的受体品种的种子死亡率会有所差异。还尝试过利用基于Foral-dip的方式,即类似于拟南芥浸花法,来进行尝试,但是结果都不尽如人意。在本研究中,创造性的提出了利用胚胎分生组织(胚芽鞘)作为农杆菌渗透的靶组织,并在T0代株系中实验验证成功,为水稻遗传转化技术的发展提供了一个新的思路。
2.5玉米体细胞胚直接转化
2018年4月,William Gordon-Kamm团队在In Vitro Cellular & Developmental Biology-Plant上发表了题为“Rapid genotype “independent” Zea mays L. (maize) transformation via direct somatic embryogenesis”的研究论文,文中提出了一种不需要经过愈伤培养阶段的高效、快速的玉米遗传转化体系。
在这项研究中,科研工作者利用发育调控因子Baby Boom(Bbm)和Wuschel2(WUS2),或者可以称为玉米形态发生转录因子,来助力这一研究。早在2016年,该团队就发现这两个基因对于提高玉米自交系转化效率发挥了巨大的作用,但是这两个基因的异位表达也会对再生植株的生长造成影响,并且会造成不育(Lowe et al., 2016)。
为了减轻Bbm/Wus2异位表达对玉米转基因植株生长以及不育的影响,团队利用特异性启动子PLTP(磷脂转移酶蛋白基因的启动子)和Axig1(生长素诱导启动子)分别驱动Bbm和Wus2来增强基因的组织和时间特异性表达,使得不依赖玉米基因型且不经过愈伤培养阶段的高效、快速的玉米遗传转化成为现实。
PLTP启动子驱动的Bbm和Axig1启动子驱动的Wus2转化玉米幼胚后,快速形成大量的体细胞胚(图10)。这些体细胞胚可以直接被转化并长成植株而不需要经过愈伤阶段,且转化植株的生长和繁殖过程均正常。此外,经过测试,该系统适用任何的玉米自交系,转化频率在9%-224%之间,优异转化事件(单拷贝且不含载体骨架)的比例在3.64%-12.5%之间。

图10 用含有Zm-Axig1pro::Wus2和Zm-PLTPpro::Bbm的T-DNA载体对未成熟胚进行农杆菌介导的转化后,玉米体细胞胚发育的组织形态(Lowe et al., 2018)。观察到的最早的形态变化是横向或斜向细胞分裂(A),其继续分裂变成多细胞(B),并生长成早期的球状原胚(C)。在发育的体细胞胚中,经常在同一横截面中观察到多个有丝分裂过程(D)。还观察到多个独立的体细胞胚相互靠近(E),随着体细胞胚的继续发育,可以观察到胚分生组织的发育(F-G)。
植物组织培养是目前使用最多的基因遗传转化的方式,但是因为受体基因型的不同,在某些物种中该技术的利用存在一定的限制。在这篇文章中,小远向大家介绍了5种不需要经过愈伤组织就能够完成转化的方法,希望能够对大家有所启迪和帮助。遗传转化的进程还在不断向前,我们期待看到破除“隔阂”的植物界全物种的遗传转化。文章至此就告一段落了,但是我们对前沿的动态会保持关注。
如果小伙伴们有想看的文章内容可以留言或者私信小远哦!我们下次再见!
References:
何伟, 朱美睿, 单海艳, 江易林, 安学丽, 万向元. 促进植物高效遗传转化的发育调节因子及其在玉米中的应用进展. 中国生物工程杂志, 2022, 42(8):85-98.
Cheng S, Huang Y, Zhu N, Zhao Y. The rice WUSCHEL-related homeobox genes are involved in reproductive organ development, hormone signaling and abiotic stress response[J]. Gene. 2014;549(2):266-274.
Cody JP, Maher MF, Nasti RA, Starker CG, Chamness JC, Voytas DF. Direct delivery and fast-treated Agrobacterium co-culture (Fast-TrACC) plant transformation methods for Nicotiana benthamiana[J]. Nat Protoc. 2023;18(1):81-107.
Cao X, Xie H, Song M, et al. Cut-dip-budding delivery system enables genetic modifications in plants without tissue culture[J]. Innovation (Camb). 2022;4(1):100345.
Jha P, Kumar V. BABY BOOM (BBM): a candidate transcription factor gene in plant biotechnology[J]. Biotechnol Lett. 2018;40(11-12):1467-1475.
Kim JH. Biological roles and an evolutionary sketch of the GRF-GIF transcriptional complex in plants[J]. BMB Rep. 2019;52(4):227-238.
Liu H, Zhao H, Wu L, et al. A genetic transformation method for cadmium hyperaccumulator Sedum plumbizincicola and non-hyperaccumulating ecotype of Sedum alfredii[J]. Frontiers in plant science, 2017, 8: 1047.
Lowe K, La Rota M, Hoerster G, et al. Rapid genotype "independent" Zea mays L. (maize) transformation via direct somatic embryogenesis[J]. In Vitro Cell Dev Biol Plant. 2018;54(3):240-252.
Lowe K, Wu E, Wang N, et al. Morphogenic Regulators Baby boom and Wuschel Improve Monocot Transformation[J]. Plant Cell. 2016;28(9):1998-2015.
Tamizi AA, Md-Yusof AA, Mohd-Zim NA, et al. Agrobacterium-mediated in planta transformation of cut coleoptile: a new, simplified, and tissue culture-independent method to deliver the CRISPR/Cas9 system in rice [published online ahead of print, 2023 Oct 11]. Mol Biol Rep. 2023;10.1007/s11033-023-08842-2.
Zuo J, Niu Q W, Frugis G, et al. The WUSCHEL gene promotes vegetative‐to‐embryonic transition in Arabidopsis[J]. The Plant Journal, 2002, 30(3): 349-359.
834

被折叠的 条评论
为什么被折叠?



